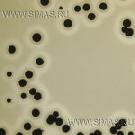

Компания СИМАС
Москва, Варшавское шоссе д.125 стр.1
+7 (495) 980 - 29 - 37, +7 (916) 942 - 65 - 95
info@simas.ru
|
Полный перечень сред Lab M
1 | 2 | 3 | 4 | 5 | 6 | 7
Harlequin CSIM (ISO) - Cronobacter sakazakii Isolation Medium
 Производитель: Lab M
Описание: Агар селективный для выделения Cronobacter sakazakii из молока и молочных продуктов по стандарту ISO/TS 22964:2006 (E)
Этап: Исследование |
|
|
Harlequin CSA-DFI - Cronobacter sakazakii Agar DFI Formulation
 Производитель: Lab M
Описание: Агар селективный для выделения Cronobacter sakazakii из молока и молочных продуктов по прописи Druggan и др.
Этап: Исследование |
|
|
Harlequin E.Coli / Coliform Medium
 Производитель: Lab M
Описание: Агар двойной хромогенный для одновременного подсчета Е.coli и колиформных бактерий.
Этап: Исследование |
|
|
Harlequin LB Agar
 Производитель: Lab M
Описание: Агар для безопасного и надежного выделения плазмидотрансформированных бактерий.
Этап: Исследование |
|
|
Harlequin LB Top Agar
 Производитель: Lab M
Описание: Топ-агар для безопасного и надежного выдеделения фаготрансформированных бактериий.
Этап: Исследование |
|
|
Harlequin Listeria Chromogenic Agar (ISO 11290)
 Производитель: Lab M
Описание: Агар хромогенный с селективной идентификацией при выделении Listeria monocytogenes и других видов листерий из продуктов (по стандарту ISO 11290).
Этап: Исследование |
|
|
Harlequin Listeria Medium
 Производитель: Lab M
Описание: Cреда селективная для выделения листерий и клинического материала и продуктов.
Этап: Исследование |
|
|
Harlequin mLGA
 Производитель: Lab M
Описание: Агар хромогенный селективный для одновременного подсчета E.coli и колиформных бактерий в воде.
Этап: Исследование |
|
|
Harlequin Salmonella ABC Medium
 Производитель: Lab M
Описание: Агар двойной хромогенный для выделения сальмонелл в продуктах (включая Salmonella typhi и S. Paratyphi).
Этап: Исследование |
|
|
Harlequin SMAC-BCIG
 Производитель: Lab M
Описание: Агар с сорбитолом и хромогенной добавкой D-глюуронидом (вариант среды МакКонки) для выделения энтеропатогенных штаммов кишечных палочек E.Coli O-157.
Этап: Исследование |
|
|
Harlequin TBGA
 Производитель: Lab M
Описание: Агар с хромогеном D-глюкуронидом для упрощения подсчета E.coli без применения мембранных фильтров.
Этап: Исследование |
|
|
Aeromonas Agar
 Производитель: Lab M
Описание: Агар с желчью, бриллиантовым зеленым и иргазаном для выделения Aeromonas spp.
Этап: Исследование |
|
|
Bacillus cereus Medium (P.E.M.B.A.)
 Производитель: Lab M
Описание: Агар селективный для выделения и подсчета B. cereus.
Этап: Исследование |
|
|
Bacillus cereus Medium (P.R.E.P.)
 Производитель: Lab M
Описание: Агар для подсчета и дифференциации B. cereus.
Этап: Исследование |
|
|
Baird-Parker Medium Base (ISO)
 Производитель: Lab M
Описание: Агар Бэйрд-Паркера для выделения и подсчета коагулозоположительных стафилококков по стандарту ISO 6888-1:1999 (включ. А1:2003).
Этап: Исследование |
|
|
Baird-Parker Medium Base
Производитель: Lab M
Описание: Агар Бэйрд-Паркера для выделения и подсчета коагулозоположительных стафилококков.
Этап: Исследование |
|
|
BCYE Legionella Isolation Medium
 Производитель: Lab M
Описание: Агар угольно-дрожжевой для выделения легионелл.
Этап: Исследование |
|
|
Bile Aesculin Agar
 Производитель: Lab M
Описание: Агар желчный с эскулином для подсчета и предварительной идентификации энтерококков.
Этап: Исследование |
|
|
Bismuth Sulphite Agar Base «A»
 Производитель: Lab M
Описание: Агар висмут-сульфитный (модифицированная среда Вильсон-Блера) для выделения Salmonella typhi.
Этап: Исследование |
|
|
Blood Agar Base
 Производитель: Lab M
Описание: Агар кровяной, как основа для приготовления сред, возможно обогащение кровью.
Этап: Исследование |
|
|
Blood Agar Base № 2
 Производитель: Lab M
Описание: Агар кровяной № 2, высокопитательная основа для сред при добавлении крови.
Этап: Исследование |
|
|
Brain Heart Infusion Agar
 Производитель: Lab M
Описание: Агар на сердечно-мозговом настое, основа питательных сред.
Этап: Исследование |
|
|
Brain Heart Infusion Broth
 Производитель: Lab M
Описание: Бульон на сердечно-мозговом настое с высокой изотоничностью, насыщен различными питательными субстратами.
Этап: Исследование |
|
|
Brazier’s CCEY Agar
 Производитель: Lab M
Описание: Агар Брэзайерса, используется как референс-среда для выделения Clostridium difficile.
Этап: Исследование |
|
|
Brilliant Green Agar (Modified)
 Производитель: Lab M
Описание: Агар с бриллиантовым зелёным, модифицированный, для селективного выделения сальмонелл (за исключением S.typhi).
Этап: Исследование |
|
|
Brilliant Green Bile 2% Broth
 Производитель: Lab M
Описание: Бульон желчный с бриллиантовым зеленым для выделения колиформных бактерий из продуктов и воды.
Этап: Исследование |
|
|
Bromocresol Purple Lactose Agar
 Производитель: Lab M
Описание: Агар лактозный с бромкрезолпурпурным для выделения и подсчета энтеробактерий.
Этап: Исследование |
|
|
Buffered Listeria Enrichment Broth
 Производитель: Lab M
Описание: Бульон cелективный забуференный для обогащения листерий в продуктах и воде.
Этап: Исследование |
|
|
Buffered Listeria Enrichment Broth PLUS
 Производитель: Lab M
Описание: Бульон забуференный ПЛЮС для обогащения листерий в продуктах и воде (полный аналог среды LAB139 без всяких добавок).
Этап: Исследование |
|
|
Buffered Peptone Water
 Производитель: Lab M
Описание: Вода пептонная забуференная для предобогащения при выделении сальмонелл из продуктов.
Этап: Исследование |
|
|
1 | 2 | 3 | 4 | 5 | 6 | 7
|